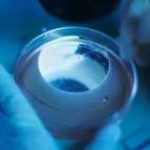
汕头三代试管PGT有几种结果

贵州省人民医院。今天,我收集了一些关于贵州三代试管婴儿医院排名?知识。希望大家都喜欢。
前身为贵州省人民医院生殖内分泌实验室的贵州省人民医院生殖中心,是贵州省首批开展女性内分泌疾病诊疗的实验室之一。试管成功率约为40%。
2.遵义医学院附属医院。
遵义医学院附属医院生殖中心成立于2000年,是贵州首批开展生殖临床实验和研究的医疗单位之一。傅晶科技于2001年11月获贵州省卫生厅批准。2006年8月16日,常规体外受精-胚胎移植(IVF-ET)在单精子卵胞浆中微注射(ICSI)胚泡培养和移植技术于2015年获得卫生部批准。30-40%的试管成功率。
3.贵阳市妇幼保健院。
贵阳妇幼保健院生殖中心成立于2000年。是贵州省首例体外受精-胚胎移植技术(IVF-ET)和ICSI。2003年,贵州省首次通过卫生部对体外受精胚胎移植的评估获得认证资格。试管成功率约为40%。
4.贵州医科大学附属医院。
贵州医科大学附属医院生殖医学中心成立于2000年,是贵州医学会生殖医学分会主席。是贵州省卫生部批准开展人类辅助生殖技术的最早单位之一。试管成功率约为40%。
黔东南中医院。
黔东南中医院生殖医学中心成立于2015年,是黔东南唯一批准开展人类辅助生殖技术的医疗机构。试管成功率为30-40%。
6.贵阳市第二人民医院。
2017年4月1日,经贵州省卫生健康委批准,贵阳市第二人民医院(金阳医院)生殖医学中心开展辅助生殖和辅助妊娠技术。是贵阳医院与关山湖区合作设立的辅助生殖技术中心,也是唯一成功率30-40%。
总结。以上就是“贵州三代试管婴儿医院排名?”的全部内容了,如果患者还有其他的疑问,欢迎免费咨询求医网生殖专家。现在很多私立机构都宣称可以做供卵试管,但大多都是没有正规资质的,患者一定要注意甄别。求医网在此助您早日好孕,顺利早日享受天伦之乐!
 瑞丁CEF国际生殖妇产医院
瑞丁CEF国际生殖妇产医院